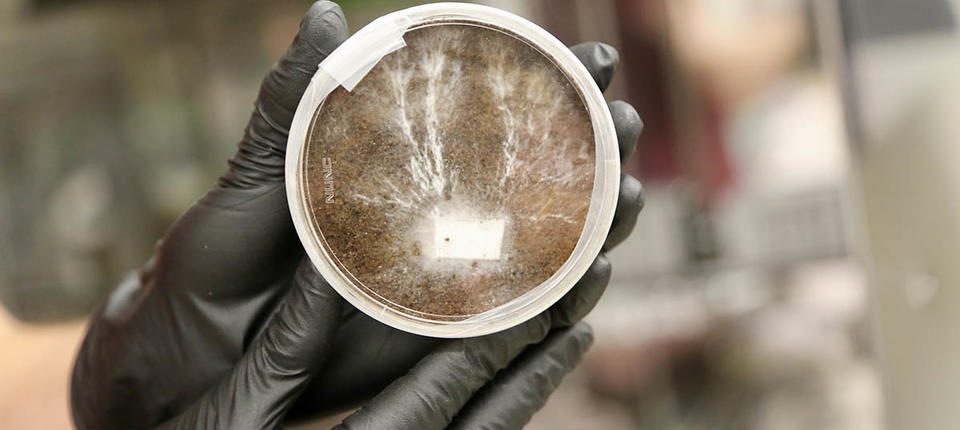
La NASA intende

Gli scienziati della NASA stanno studiando una strategia speciale per costruire basi sulla Luna e su Marte: coltivarle in loco da funghi vivi.
L'idea è di inviare il fungo dormiente sulla luna e, una volta arrivato, dargli l'acqua e le condizioni necessarie per crescere, secondo un comunicato stampa della NASA. Richiederebbe anche una scorta di batteri fotosintetici per fornire nutrienti al fungo. Una volta che il fungo ha assunto la forma di una struttura, viene trattato termicamente, uccidendolo efficacemente e trasformandolo in un mattone compatto.
La NASA sogna di costruire case per gli umani su Marte, ma non è facile imballare tonnellate di materiali da costruzione e portarli nello spazio sul Pianeta Rosso. Questo è il motivo per cui l'agenzia è interessata a idee alternative, inclusa la possibilità di “case in crescita”.
Il programma Innovative Advanced Concepts (NIAC) della NASA ha finanziato la ricerca sulla fattibilità dei processi di micoarchitettura che potrebbero utilizzare i funghi per coltivare habitat sulla Luna e su Marte.
Il concetto si concentra sulla parte miceliale del fungo. “Questi minuscoli filamenti creano strutture complesse con estrema precisione, combinandosi in strutture più grandi come i funghi”, ha detto la NASA in una dichiarazione martedì. L'agenzia ha pubblicato un video che descrive l'idea dell'habitat e mostra alcuni concept art.
Il concetto di habitat include una cupola a tre strati composta da acqua ghiacciata all'esterno; cianobatteri (che producono ossigeno e sostanze nutritive) nel mezzo; e lo strato interno di micelio, che si nutre e cresce intorno all'impalcatura per creare una casa su Marte.
La NASA ha detto che la struttura sarà “preparata per uccidere le forme di vita, garantendo l'integrità strutturale e prevenendo la contaminazione di Marte e di qualsiasi forma di vita microbica già esistente”.
I ricercatori hanno già sperimentato la creazione di oggetti utilizzando il micelio. Un team delle Università di Stanford e Brown ha sollevato uno sgabello completamente utilizzabile come parte di un progetto di micoarchitettura presso l'Ames Research Center della NASA nel 2018. Dopo due settimane di crescita, le feci sembravano qualcosa di dimenticato da tempo in frigorifero.

Questo sgabello è stato coltivato dal micelio in un esperimento del 2018. 2018 Stanford-Brown-RISD iGEM Team
Le idee alla base dell'habitat su Marte potrebbero essere potenzialmente trasferite per la costruzione sulla Terra.
La ricerca è ancora nelle fasi iniziali, ma mostra come gli scienziati stiano lavorando per espandere gli orizzonti quando si tratta di futuri habitat umani al di fuori della Terra.
Fonti: Foto: 2018 Stanford-Brown-RISD iGEM Team






